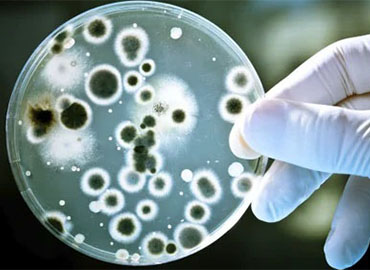

At Lotus Water Food Testing and Research Laboratory Pvt Ltd, we are committed to safeguarding public health and ensuring the integrity of water and food supplies. Our dedication to excellence, customer satisfaction, and scientific integrity sets us apart as a premier testing laboratory.
Contact Us
-
-
-
Address
29 & 38, First Floor, F block. Sanghavi Steel Complex, Chinchwad, Pune 411019
Locate Us
Copyright © Lotus Lab. All rights reserved.
Designed by Netcom Business Solutions